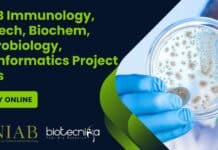
NIAB Immunology, Biotech, Biochem, Microbiology, Bioinformatics Project Jobs, Apply Online NIAB Immunology

Pepsi India R&D Spec Writing Role For BS, MSc Food Tech, Microbiology Candidates
Pepsi India R&D Spec Writing Role For BS, MSc Food Tech, Microbiology Candidates
Pepsi India R&D Spec Writing Role For BS, MSc Food Tech, Microbiology...
NIAB Immunology, Biotech, Biochem, Microbiology, Bioinformatics Project Jobs, Apply Online
NIAB Immunology, Biotech, Biochem, Microbiology, Bioinformatics Project Jobs, Apply Online
NIAB Immunology, Biotech, Biochem, Microbiology, Bioinformatics Project Jobs, Apply Online. National Institute of Animal Biotechnology...
How To Crack CSIR NET Life Science Exam in 50 Days? Download Day Wise...
Qualify CSIR NET In 50 Days
The CSIR NET Life Science exam is one of the most challenging exams for life sciences in India. It...
Pepsi Microbiology, Food Science, Food Tech Job Opportunity For BSc, MSc Candidates
Pepsi Microbiology Job, Food Science, Food Tech Job Opportunity For BSc, MSc Candidates
Pepsi Microbiology Job, Food Science, Food Tech Job Opportunity For BSc, MSc...
Clarivate MSc Life Science, Biotech, Microbiology & Biophysics Job Opening, Apply Online
Clarivate MSc Life Science, Biotech, Microbiology & Biophysics Job Opening, Apply Online
Clarivate MSc Life Science, Biotech, Microbiology & Biophysics Job Opening, Apply Online. MSc...
Clarivate Drug Safety Content Specialist Job For MSc Biotech, Biochem, Life Sciences
Clarivate Drug Safety Content Specialist Job For MSc Biotech, Biochem, Life Sciences
Clarivate Drug Safety Content Specialist Job For MSc Biotech, Biochem, Life Sciences,...
DNV India In-Vitro Diagnostic Assessors Role For Biochem, Biology & Microbiology Candidates
DNV India In-Vitro Diagnostic Assessors Role For Biochem, Biology & Microbiology Candidates
DNV India In-Vitro Diagnostic Assessors Role For Biochem, Biology & Microbiology Candidates. In-Vitro...
Biotecnika Times Newsletter 11.04.2023 Freshers Jobs, Research Associate Fellowship Programme, CSIR NET Notes, CSIR...
Biotecnika Times Newsletter 11.04.2023 Freshers Jobs, Research Associate Fellowship Programme, CSIR NET Notes, CSIR Exam Application Date Extended
Freshers Graduate/Post Graduate Life Sciences QA Job...
57 Days To Success in CSIR NET – An Exclusive CSIR NET Podcast By...
Biotecnika Success Podcast - An Exclusive CSIR NET Podcast - Episode 3
Welcome to Episode 3 of the Success Podcast
An exclusive CSIR NET podcast initiative...
Clarivate MSc, PhD Life Sciences Job For Candidates With <1 Year Exp, Apply Online
Clarivate Content Editor Job For MSc, PhD Life Sciences Candidates, Apply Online
Clarivate Content Editor Job For MSc, PhD Life Sciences Candidates, Apply Online. MSc...
Reliance Industries Limited Analyst Job For Candidates From 0-5 Years Exp
Reliance Industries Analyst Job For Candidates From 0-5 Years Exp
Reliance Industries Analyst Job For Candidates From 0-5 Years Exp. Biochemistry and Biotechnology candidates with...
Pepsico Food Sciences R&D Scientist Job For MSc & PhD Candidates, Apply Online
Pepsico Food Sciences R&D Scientist Job For MSc & PhD Candidates, Apply Online
Pepsico Food Sciences R&D Scientist Job For MSc & PhD Candidates, Apply...
CCRAS Funded JRF Job at BHU – MSc Botany, Biotech & Life Sciences Apply
BHU JRF Job 2023 - MSc Botany, Biotech & Life Sciences Apply
BHU JRF Job 2023 - MSc Botany, Biotech & Life Sciences Apply. Banaras...
Research Associate Fellowship Programme 2023 at Botanical Survey of India
Research Associate Fellowship Programme 2023 at Botanical Survey of India
Research Associate Fellowship Programme 2023 at Botanical Survey of India. Interested and eligible applicants can...
Don’t Skip CSIR NET UNIT 9 – Revise With Quick Revision Concept Table PDF...
CSIR NET UNIT 9 - Diversity of Life Forms focuses on the diversity of life forms and carries an average weightage of 20 marks...